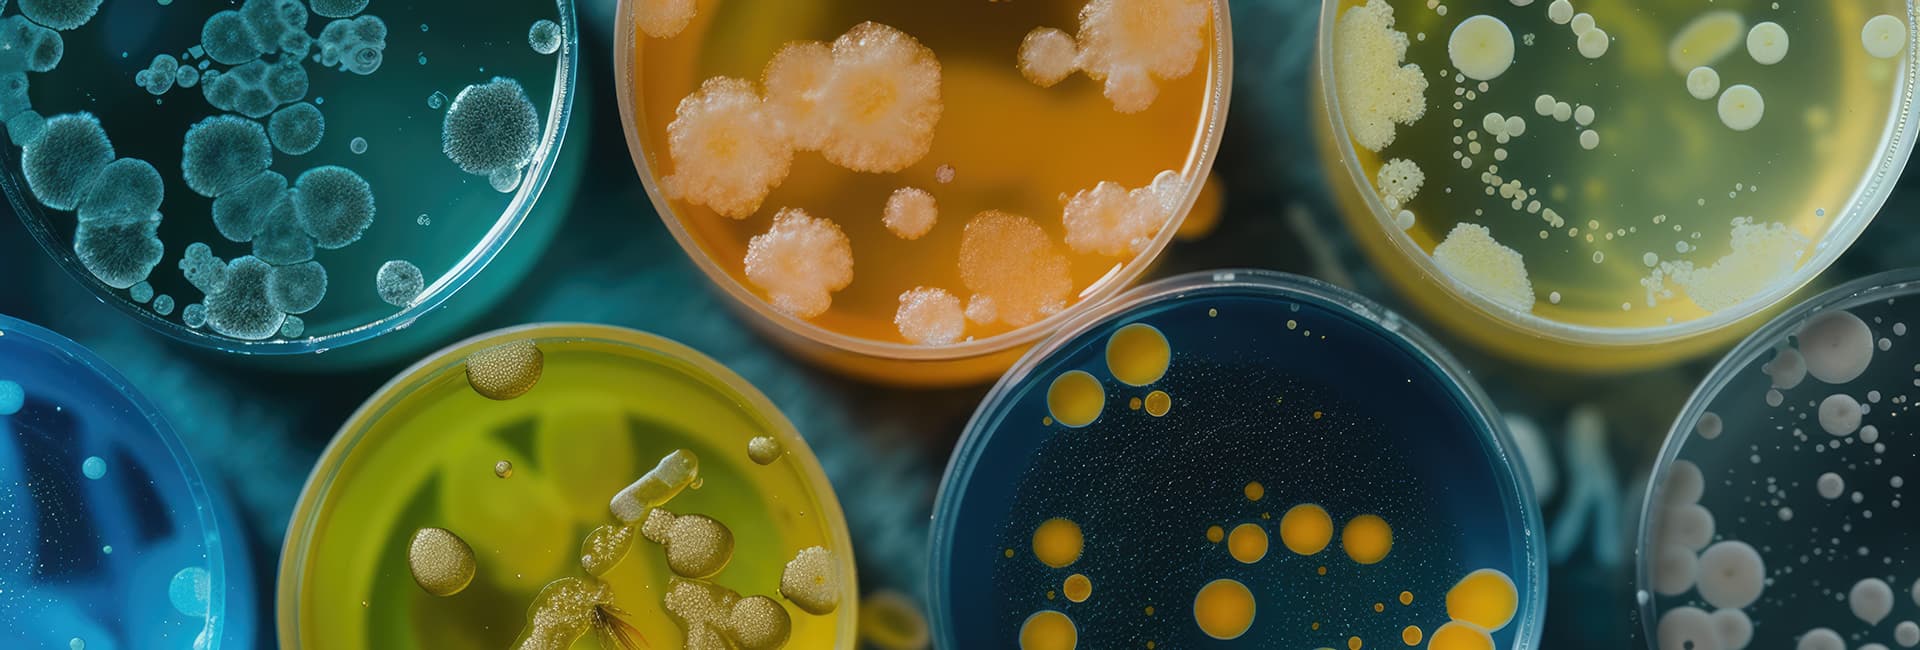

WATER ANALYSIS
Σκοπός των αναλύσεων νερού είναι η διασφάλιση της ποιότητας και η εξασφάλιση της δημόσιας υγείας. Το IWaterFood έχει πολύχρονη και εξειδικευμένη εμπειρία, ειδικευμένο προσωπικό και τον πιο σύγχρονο εξοπλισμό.

FOOD ANALYSIS
Οι μικροβιολογικοί κίνδυνοι στα τρόφιμα αποτελούν μία από τις κυριότερες πηγές τροφιμογενών ασθενειών στον άνθρωπο. Στόχος των αναλύσεων τροφίμων είναι η παροχή ασφαλών τροφίμων στους καταναλωτές και η διασφάλιση της δημόσιας υγείας.

WASTEWATER ANALYSIS
Το IWaterFood είναι διαπιστευμένο από τον ΕΣΥΔ και στις αναλύσεις λυμάτων. Στόχος μας είναι η διασφάλιση της δημόσιας υγείας και η προστασία του περιβάλλοντος.